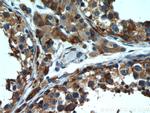
Tim23 Antibody in Immunohistochemistry (Paraffin) (IHC (P))
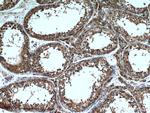
Tim23 Antibody in Immunohistochemistry (Paraffin) (IHC (P))

Search
Proteintech
Tim23 Polyclonal Antibody
{{$productOrderCtrl.translations['antibody.pdp.commerceCard.promotion.promotions']}}
{{$productOrderCtrl.translations['antibody.pdp.commerceCard.promotion.viewpromo']}}
{{$productOrderCtrl.translations['antibody.pdp.commerceCard.promotion.promocode']}}: {{promo.promoCode}} {{promo.promoTitle}} {{promo.promoDescription}}. {{$productOrderCtrl.translations['antibody.pdp.commerceCard.promotion.learnmore']}}
产品信息
11123-1-AP
种属反应
已发表种属
宿主/亚型
分类
类型
抗原
偶联物
形式
浓度
规格
纯化类型
保存液
内含物
保存条件
运输条件
产品详细信息
Immunogen sequence: MEGGGGSGN KTTGGLAGFF GAGGAGYSHA DLAGVPLTGM NPLSPYLNVD PRYLVQDTDE FIPTGANKTR GRFELAFFTI GGCCMTGAAF GAMNGLRLGL KETQNMAWSK PRNVQILNMV TRQGALWANT LGSLALLYSA FGVIIEKTRG AEDDLNTVAA GTMTGMLYKC TGGLRGIARG GLTGLTLTSL YALYNNWEHM KGSLLQQSL (1-208 aa encoded by BC062707 )
靶标信息
Essential component of the TIM23 complex, a complex that mediates the translocation of transit peptide-containing proteins across the mitochondrial inner membrane.
仅用于科研。不用于诊断过程。未经明确授权不得转售。
生物信息学
蛋白别名: membrane protein; Mitochondrial import inner membrane translocase subunit Tim23; predicted protein of HQ1197; translocase of inner mitochondrial membrane 23 homolog; translocase of the inner mitochondrial membrane; unnamed protein product
基因别名: TIM23; TIMM23
UniProt ID: (Human) O14925, (Rat) O35093
Entrez Gene ID: (Human) 100287932, (Rat) 54312, (Mouse) 53600